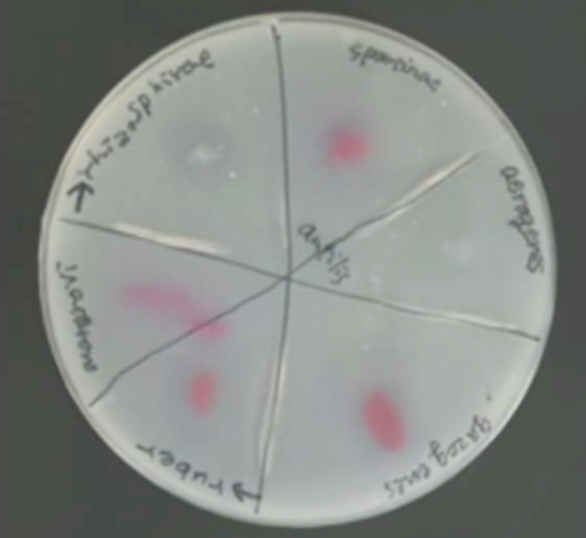

Since the early 1990s, PBS has been increasingly used in industrial plastics such as mulch films, compostable bags and foodservice packaging. This polymer ends up in the ocean with a lot of discarded plastic, and unfortunately, it doesn’t biodegrade well in the marine environment.
Recently, researchers from Hokkaido University collaborated with colleagues from Japan’s Mitsubishi Chemical Group to discover specific marine bacteria that can degrade PBS. The researchers analyzed the impact of microorganisms collected from natural seawater offshore Japan on PBS and found that three species of marine Vibrio bacteria can degrade PBS. Relevant papers have been published in the international journal Environmental Microbiology.

The researchers also discovered the enzyme responsible for degrading PBS in a specific strain of bacteria called Vibrio ruber. They named the enzyme PBSase.
Then, they further used molecular biology techniques to insert the PBSase gene into common bacteria E. coli and cultured high-purity enzyme samples for further research.
The researchers said that this study elucidates the degradation mechanism in seawater at the molecular level and will help develop new polymers for marine biodegradation in the future.
This research is part of a broader effort to address the complexities of biodegradable polymer technology due to their differential biodegradability on land and in the ocean. By learning more about the factors that control biodegradability in different environments, scientists can hopefully develop polymers that are best suited to the environment in which they are used and the environments likely to arise after use.

 微信扫一扫打赏
微信扫一扫打赏

